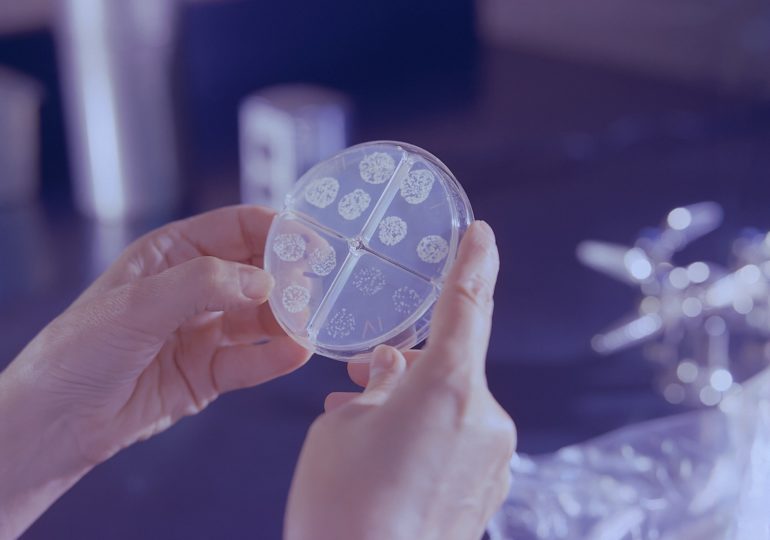
В Самарской области заболеваемость туберкулезом снизилась в три раза

В регионе каждый год фиксируют все меньше заболевших туберкулезом. За последние несколько лет их стало в три раза меньше. Как отметила заместитель главного врача Самарского областного клинического противотуберкулезного диспансера имени Н.В. Постникова…
Метка: туберкулёз
В России успешно испытали вакцину от туберкулеза для взрослых
Эксперты из Научного центра трансляционной медицины Университета «Сириус», проведя исследование, представили свою разработку мРНК-вакцины от туберкулеза, которая была разработана весной этого года. Результаты исследования показали, что новый препарат является наиболее…
В Самарской области приставы принудительно госпитализировали женщину с открытой формой туберкулеза
В Безенчукском районе приставы госпитализировали женщину с открытой формой туберкулеза. Об этом сообщили в региональном УФССП. — Имея открытую форму туберкулеза, женщина уклонялась от лечения и подвергала опасности окружающих. Ранее…
В Самарской области снизилась динамика заболеваемости туберкулёзом
В среду, 23 марта, в Самарском доме журналиста и литератора прошла пресс-конференция, посвященная дню борьбы с туберкулёзом. Руководитель управления организации социально значимой и специализированной медицинской помощи Илья Сиротко поблагодарил коллег…
В Самарской области больного туберкулезом заставили лечиться
Жителя Кошкинского района заставили пройти лечение в противотуберкулезном диспансере. Об этом сообщили в УФССП России по Самарской области. — Мужчина страдал открытой формой туберкулеза и не хотел проходить лечение. Так,…
На Нагорной строят корпус для пациентов психбольницы с туберкулезом
В Самаре возводят модульное здание для пациентов областной клинической психиатрической больницы. Здесь будут размещать больных с туберкулезом. Новое здание возводят по адресу: Нагорная, 78. Противотуберкулезное отделение будет рассчитано на 70…
Больного туберкулёзом из Самарской области силой отправили в диспансер
Жителя Отрадного с заразной формой туберкулёза принудительно госпитализировали в больницу. Соответствующее решение принял городской суд. Сотрудники прокуратуры выяснили, что 44-летний житель города состоит на учете в противотуберкулезном диспансере. — Он…